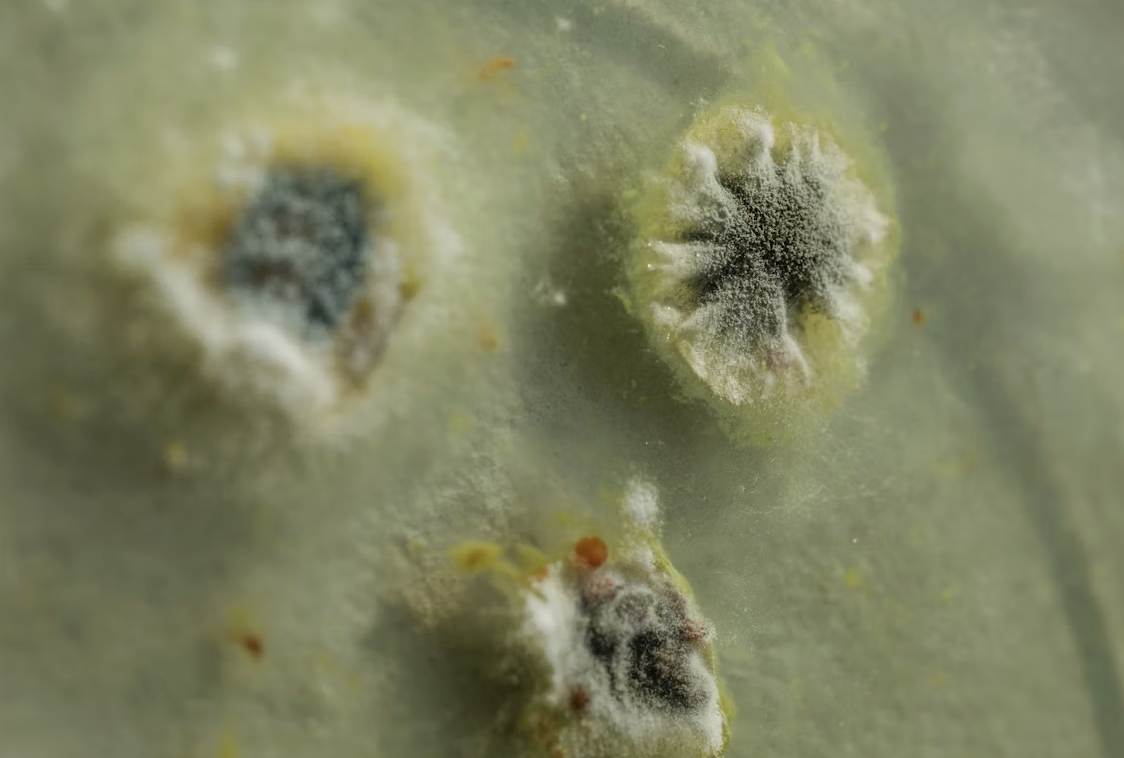

Ini 7 Makanan Yang Berisiko Mengandungi Kulat Tersembunyi Walaupun Kelihatan Masih Elok
Lina Rosli
Siapa dalam kalangan anda yang mempunyai tabiat yang cenderung dalam menggunakan sesuatu bahan hingga ke saat-saat akhir – yang mana selagi ia kelihatan masih elok, ia akan digunakan sehingga habis.
Secara umumnya, tabiat ini tidak salah dan adalah sangat dituntut kerana ia secara tidak langsung dapat mengurangkan pembaziran. Walau bagaimanapun, untuk sesetengah bahan atau produk makanan sebenarnya cenderung dalam mengandungi kulat yang tersembunyi.
Untuk pengetahuan anda, kulat merupakan sebahagian daripada proses semula jadi pereputan makanan. Dan jika dimakan atau dikonsumsi, ia boleh memberikan risiko kepada kesihatan.

Pada sesetengah makanan juga, tanda kulat boleh menjadi tidak jelas – lebih-lebih lagi pada permukaan. Namun, hakikatnya, ia mungkin bersembunyi atau tumbuh pada ruang-ruang liang yang tidak begitu kelihatan.
Oleh yang demikian, menurut pakar keselamatan makanan, terdapat beberapa jenis makanan yang perlu dibuang segera – terutama sekali apabila ia mula menunjukkan tanda-tanda kulat walaupun hanya sedikit.
Berikut adalah jenis makanan yang perlu anda beri perhatian sekiranya ia sudah berada di meja atau dapur untuk tempoh yang lama.
#1 Roti
Roti sering menjadi tempat kulat muncul kerana kandungan lembapnya. Akar kulat, atau hyphae, boleh merebak ke seluruh roti dalam tempoh yang singkat.
Oleh itu, memotong bahagian berkulat sahaja tidak menjamin keselamatan, dan keseluruhan loaf sebaiknya dibuang.

#2 Keju Lembut
Keju lembut seperti krim keju, ricotta, mozzarella segar dan keju kotej mempunyai kandungan air yang tinggi.
Oleh yang demikian, kulat dapat menembusi ke bahagian dalam keju, menjadikannya tidak selamat untuk dimakan. Sebaliknya, keju keras atau matang boleh dipotong dengan jarak satu inci di sekeliling bahagian berkulat.

#3 Cendawan Atau Sayuran Lembut
Selain itu, sayuran seperti cendawan atau tomato turut mudah untuk dihinggapi kulat. Ini kerana ia mempunyai tekstur yang berair – menjadikannya ia mudah untuk rosak.
Kebiasaannya, untuk sayuran seperti ini, ia akan muncul kulat berwarna putih atau kelabu yang jenis berbulu yang mana ia akan membentuk tompokan pada bahagian permukaan sayuran jika ia dibiarkan lebih lama. Malahan, kulat-kulat ini turut akan berkembang jauh ke dalam liang makanan.
Makanya, jika sayuran ini sudah berkulat, adalah disarankan untuk anda buang sepenuhnya dan tidak memotong hanya bahagian yang berkulat sahaja.
#4 Buah-Buahan Lembut
Buah-buahan dengan kulit nipis dan kandungan air tinggi, seperti beri, pic, plum dan biji delima juga sangat mudah dijangkiti kulat.
Oleh itu, bagi mengurangkan risiko ia berkulat, anda disarankan untuk tidak mencuci buah sebelum disimpan dan memeriksa tanda-tanda kerosakan seperti perubahan warna, bau masam, atau kelembapan berlebihan setiap hari.

#5 Yogurt Dan Cecair Semi-Padat
Produk seperti yogurt dan sos berkrim boleh menjadi medium pertumbuhan kulat. Sekiranya kulat kelihatan, makanan tersebut perlu dibuang sepenuhnya kerana risiko mycotoxin yang boleh menjejaskan kesihatan, termasuk masalah gastrousus, ruam kulit atau sakit kepala.
#6 Sos Dan Perencah
Seterusnya, bahan-bahan dapur di dalam botol seperti sos dan perencah – sebagai contoh sos tomato atau kicap turut cenderung untuk dihinggapi kulat pada bahagian penutup dan juga di atas cecair. Keadaan ini berlaku jika ia disimpan terlalu lama.
Sekiranya terdapat tanda kulat, keseluruhan bekas perlu dibuang. Untuk mengelakkan pembaziran, pertimbangkan untuk membekukan bahagian kecil jika tidak habis digunakan dalam masa singkat.
#7 Lebihan Makanan
Akhir sekali, lebih lauk atau makanan yang disimpan di dalam bekas pakai buang yang disimpan di dalam peti sejuk turut mudah menjadi medium pertumbuhan kulat.
Jadinya, jika terdapat tanda kulat, keseluruhan hidangan perlu dibuang kerana pencemaran kemungkinan besar telah merebak di seluruh makanan.
Secara umumnya, anda mungkin berasakan yang mana kulat mungkin kelihatan tidak berbahaya. Namun, untuk kebanyakan kes, kulat ini sebenarnya boleh membawa kepada risiko kesihatan yang serius.
Oleh itu, amalkan penyimpanan yang betul, periksa makanan secara kerap dan jangan cuba menyelamatkan makanan lembap atau berkulat. Keselamatan makanan adalah keutamaan, dan pencegahan adalah langkah terbaik.